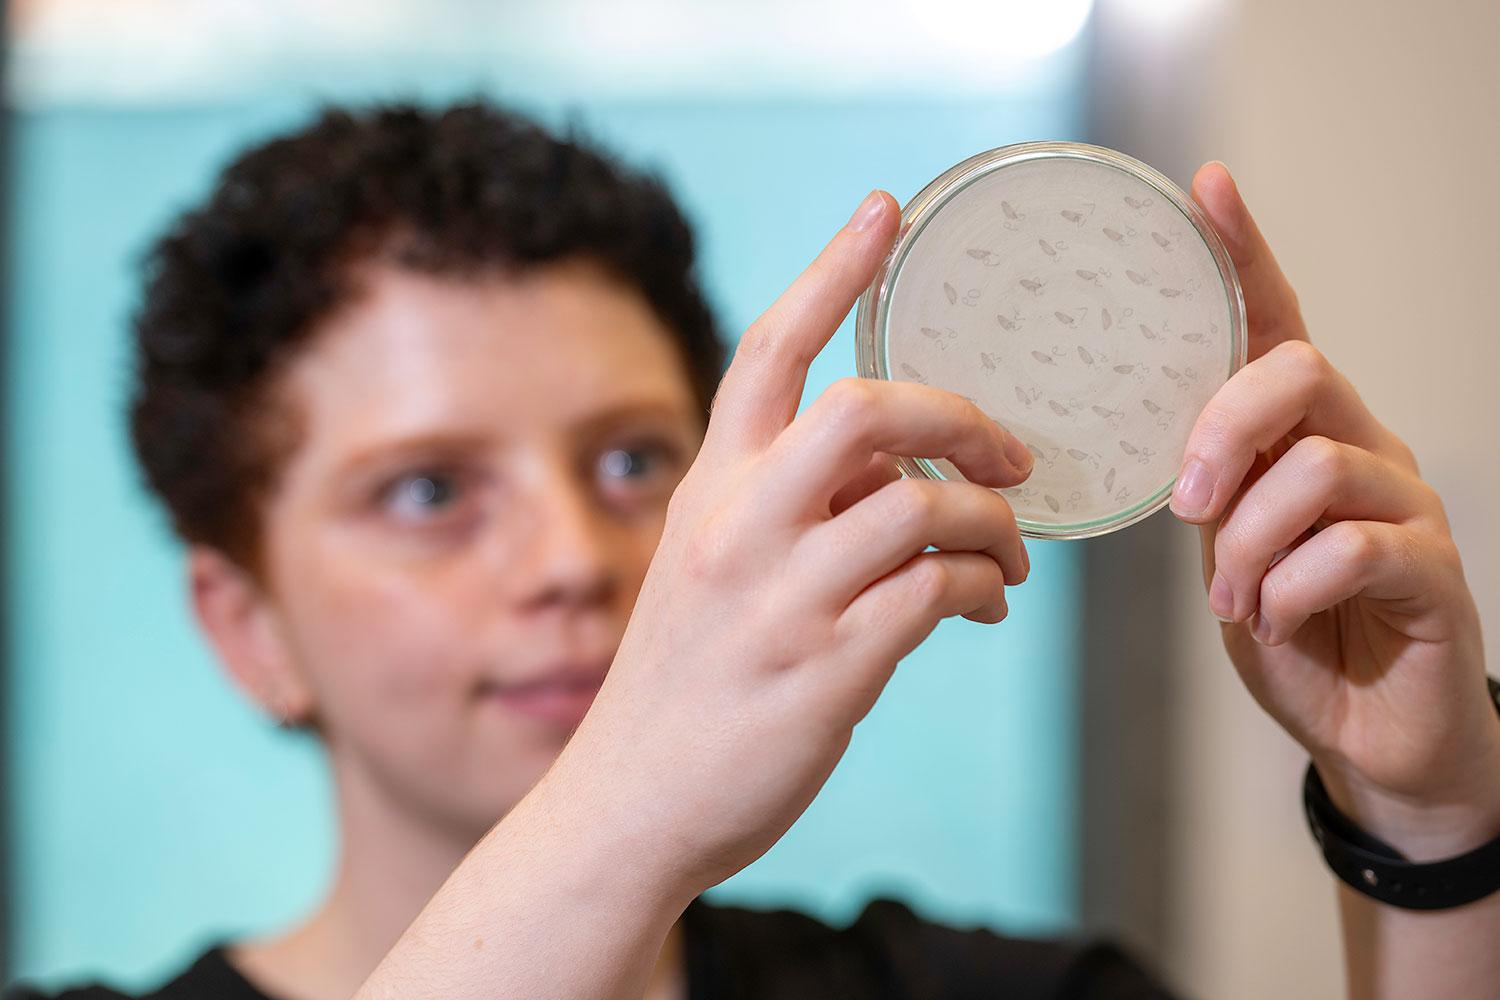
Person holding a petri dish looking up

At The Pirbright Institute we’re committed to training the next generation of scientists.
Our education programme provides unique opportunities to work alongside world-leading experts in viral diseases of livestock and to contribute to the protection of animal and human health.
We offer a limited number of internships for undergraduate students seeking a placement year.
For postgraduates, we have a diverse portfolio of PhD studentship projects.